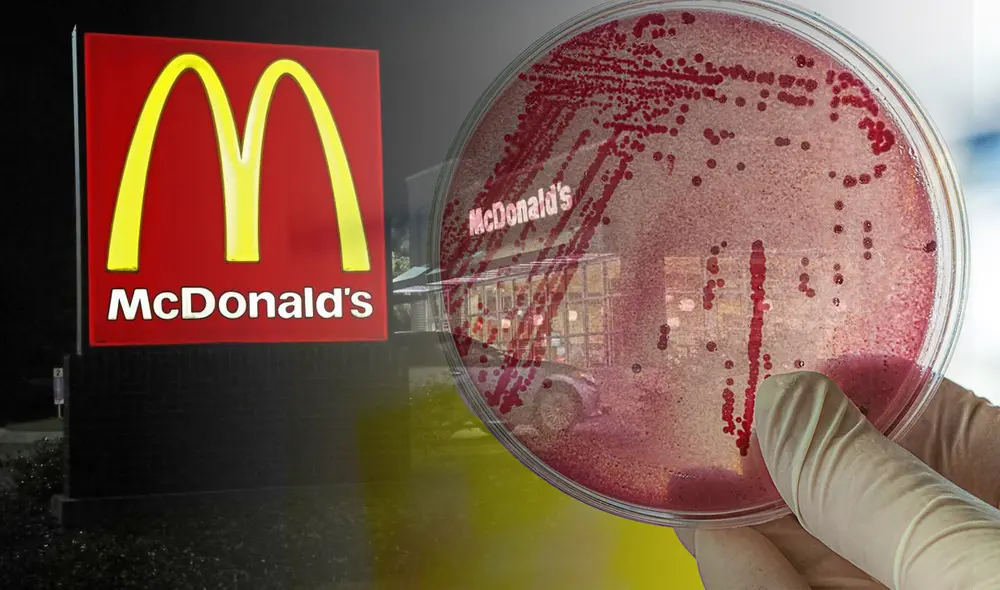
Mc Donald's colabora con la investigación por parte de Estados Unidos. Foto: composición LR/difusión

Estados Unidos investiga brote de E. coli en hamburguesas de McDonald's: 1 muerto y 49 casos reportados
Las autoridades investigan el origen del brote, que podría tener consecuencias importantes para la cadena de comida rápida en Estados Unidos.
El Centro para el Control y la Prevención de Enfermedades (CDC) en Estados Unidos ha confirmado que investiga un brote de la bacteria Escherichia coli (E. coli) relacionado con hamburguesas consumidas en la cadena McDonald’s. El brote ha dejado una persona fallecida y al menos 49 casos reportados en varios estados. Las autoridades han advertido sobre la gravedad de la situación, ya que la bacteria E. coli puede causar enfermedades graves y, en algunos casos, ser letal.
El caso ha generado gran preocupación, no solo entre los consumidores, sino también en el ámbito sanitario y regulador. McDonald’s, una de las cadenas más grandes del mundo, enfrenta una investigación que podría afectar significativamente su reputación. Las autoridades han instado a los consumidores a estar atentos a los síntomas y a buscar atención médica si han consumido hamburguesas de la cadena recientemente.
¿Qué es E. coli y cómo afecta a la salud del humano?
La bacteria Escherichia coli es comúnmente encontrada en el intestino de los humanos y animales. Sin embargo, ciertas cepas, como la E. coli O157, pueden provocar infecciones graves. Los síntomas de una infección por E. coli incluyen diarrea severa, dolor abdominal y, en casos extremos, insuficiencia renal. Estas cepas suelen transmitirse por el consumo de alimentos contaminados, como carne mal cocida o productos no pasteurizados.
Los casos recientes en Estados Unidos han sido vinculados a la ingesta de hamburguesas contaminadas. Las autoridades sospechan que la fuente de la contaminación podría estar en la cadena de suministro de carne utilizada por McDonald’s. La rápida propagación del brote ha hecho que el CDC emita advertencias a nivel nacional y recomiende a la población estar alerta.

E. coli ha dejado un fallecido y autoridades investigan a Mc Donald's. Foto: difusión
Estados Unidos investiga a Mc Donald's por brote de E. coli
McDonald’s, al ser una de las cadenas de comida rápida más grandes del mundo, está en el centro de la atención. Las investigaciones preliminares han llevado a la compañía a retirar productos de ciertas localidades, mientras las autoridades siguen investigando el origen del brote. En un comunicado, la empresa aseguró que está colaborando con las autoridades y tomando las medidas necesarias para garantizar la seguridad alimentaria de sus clientes.
Este incidente podría tener consecuencias a largo plazo para la cadena, ya que afectaría no solo su imagen, sino también su relación con proveedores y consumidores. El impacto en la industria alimentaria es también considerable, ya que pone de relieve la importancia de la seguridad alimentaria y los controles sanitarios en las cadenas de producción y distribución de alimentos.

Una de las cadenas de Mc donald's. Foto: difusión
¿Cuáles son las medidas de prevención para el E. coli?
Ante este brote de E. coli, el CDC ha emitido una serie de recomendaciones para minimizar los riesgos de contagio. Entre las medidas más importantes se encuentra la correcta cocción de las carnes, especialmente las hamburguesas, que deben alcanzar una temperatura interna de al menos 70 °C para matar cualquier bacteria. Además, se recomienda evitar el consumo de productos lácteos no pasteurizados y lavar adecuadamente frutas y verduras antes de consumirlas.
Las autoridades también sugieren a las personas que presenten síntomas, como diarrea, vómitos o dolor abdominal, que acudan inmediatamente al médico, ya que una atención temprana puede prevenir complicaciones graves. Asimismo, han instado a los establecimientos de comida rápida y restaurantes a reforzar los controles sanitarios y la capacitación de su personal en buenas prácticas de manipulación de alimentos.
























